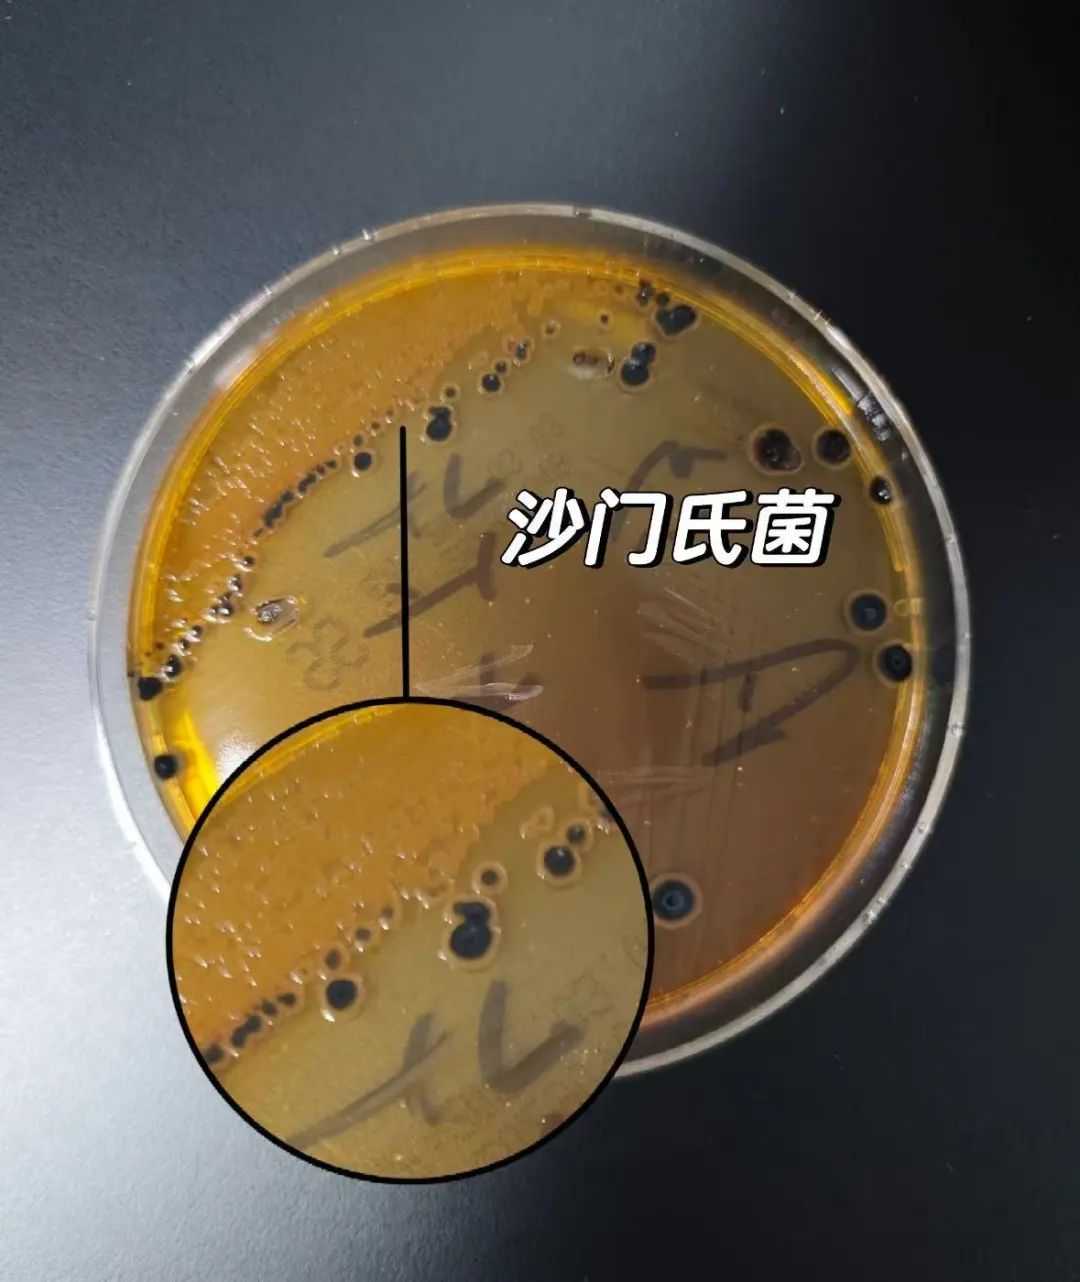
2沙门氏菌.png

无菌蛋=没细菌?可生食蛋=放心直接吃?小小鸡蛋营养大揭秘
溏心蛋、温泉蛋、生鸡蛋拌牛肉饭……说到这些,是不是口水都要流出来了?

近日,“无菌蛋智商税”相关话题冲上热搜第一。
近几年来,很多人被无菌蛋“种草”。不少商家宣称:“此种鸡蛋不含沙门氏菌、无蛋腥味、蛋黄更黄(含有β-胡萝卜素)、可以生食”。相比普通鸡蛋,无菌蛋的身价较高,有的精品无菌蛋价格是普通鸡蛋的3至4倍。
无菌蛋是否真的没有细菌?它和普通鸡蛋的营养价值有什么区别?生吃无菌蛋是否真的营养好吸收?
1、“无菌蛋”其实是“少菌蛋”

无菌蛋(图片来源于社交平台)
所谓无菌蛋,一般指经过巴氏杀菌以及严格加工处理过的鸡蛋。这种鸡蛋内细菌含量很少,但并非完全无菌,称其为“少菌蛋”更合适。
沙门氏菌是一种常见的食源性致病菌,人们日常吃的肉、蛋、奶中都可能有沙门氏菌。这种细菌怕热、不怕冷,有很强的耐低温性,可在冰箱存活3至4月之久。当环境温度达到100摄氏度时,沙门氏菌就会直接死亡。
沙门氏菌(图片来源于社交平台)
沙门氏菌进入鸡蛋通常有两种途径:
第一种途径是通过感染母鸡进入鸡蛋,沙门氏菌从母鸡的体内进入蛋黄和蛋清;
第二种途径是从粪便和泥土中进入鸡蛋内,因为蛋壳是多孔结构,沙门氏菌可附着在蛋壳表面再进入鸡蛋。
因此,要生产所谓的“无菌蛋”,企业就会从鸡苗、饲料、饮水、养殖环境以及蛋的包装、运输等所有可能感染沙门氏菌的环节来控制微生物。
比如,企业在挑选鸡苗时会选择健康的鸡苗,饲养时会用更安全的饲料和水,养殖过程中对病鸡、鸡粪等的处理要求也会更高。
最后,产出来的鸡蛋还会经过巴氏杀菌工艺的处理,之后再通过对鸡蛋的包装、运输和储存等全过程进行控制,达到“无菌”的状态。
无菌蛋一般颜色为棕黄色,里面的蛋黄也是暗黄色,看起来更像土鸡蛋,而普通鸡蛋一般颜色为白色,稍暗的颜色约为黄色。
2、无菌蛋更有营养吗?
有些商家会宣称“无菌蛋”富含有机硒、卵磷脂、优质蛋白等营养物质,给人的感觉似乎是比普通鸡蛋更有营养。
维生素、有机硒和叶黄素等营养物质,无菌蛋的含量确实比普通鸡蛋更高。但商家宣称的那些营养,并不是“无菌蛋”独有的,普通鸡蛋也有。
鸡蛋本身就富含优质蛋白、卵磷脂和维生素A、氨基酸等营养物质,这与是不是“无菌蛋”没有关系。至于硒等营养物质,也完全可以通过饲料添加来实现,跟是否无菌也没有关系。
此外,鸡蛋是否有腥味主要与饲料及鸡的品种有关。若饲料中含有菜籽粕、菜籽油、鱼粉或氯化胆碱时,食用此饲料的鸡产生的腥味物质就较多,生产的鸡蛋腥味也就较重。
通过品种选择及饲料调配,就可控制鸡蛋是否有腥味,这不是无菌蛋特有的品质。
3、吃生鸡蛋比熟鸡蛋更好吗?
一般而言,达标的无菌蛋可以生食。但是,经过巴氏杀菌后,无菌蛋只是最大程度降低了鸡蛋受沙门氏菌污染的风险,并不代表风险绝对不存在。

食用无菌蛋(图片来源于社交平台)
生吃鸡蛋除了会产生感染风险外,也不利于人体消化和吸收。
有研究显示,水煮蛋中91%蛋白质可被人体吸收,而生吃的话,这个数值约为55%。因为生鸡蛋中含有一些蛋白酶抑制剂,会影响蛋白质的消化吸收。此外,生吃鸡蛋还会影响人体对B族维生素的吸收。
所以,一些本身消化系统就不好的人群,以及老人、孕妇、小孩等,建议不要生吃蛋类。
4、无抗蛋又是什么?
从字面解释,无抗蛋就是无抗生素残留的鸡蛋。不过,这并不代表完全没有用抗生素,而是仪器检测不出来。这是无抗鸡蛋售卖的最低标准。

无抗蛋(图片来源于社交平台)
所以,购买无抗蛋时,需认准“中国有机产品”标志,或者找商家要检测报告,警惕虚假认证。
通常无抗鸡蛋的蛋黄大,蛋白浓厚,无腥无异味,胶原蛋白黏稠度大、细嫩,易被人体消化吸收,富含硒、锌、虾青素等物质,还含有大量的卵磷脂等。不过,这些营养物质普通鸡蛋也有,只是口感略有不同。
5、如何选购鸡蛋?
购买鸡蛋时,不用纠结蛋壳或蛋黄的颜色。应尽量到正规的超市、电商平台或者大型农贸市场挑选。
不用刻意买土鸡蛋。实际上,普通鸡蛋、土鸡蛋的营养价值没有差异,而土鸡蛋因为饲养环境难以保障,可能有更多的重金属等环境污染物残留。
其实,普通鸡蛋通过高温加热,其所含的致病微生物都会被杀死,因此没必要过度追求无菌。






 网站首页
网站首页
 政府信息公开
政府信息公开
 办事服务
办事服务
 互动交流
互动交流

 党建栏目
党建栏目

 蒙公网安备15040402000176号
蒙公网安备15040402000176号

